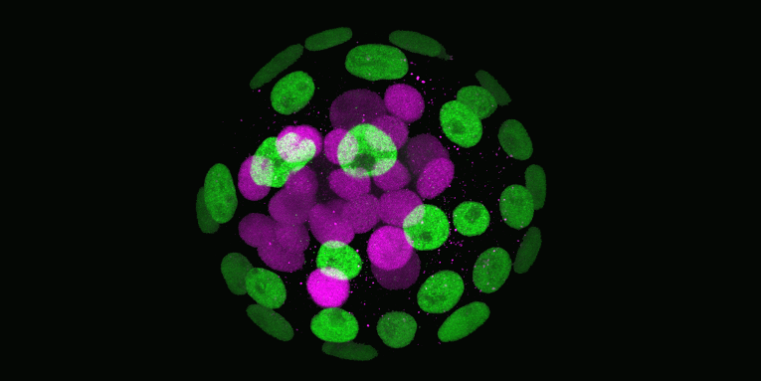

The precise spatial and temporal organization of cellular differentiation, essential for organismal development and physiology, depends on the correct formation and function of cellular interfaces. These interfaces facilitate the efficient transfer of materials and information between cells, through the dynamic assembly of molecular platforms at the plasma membrane. Such platforms integrate external and internal signals and transduce mechanical forces, guiding development and ensuring correct responses to physiological and pathophysiological changes. The Collaborative Research Center (CRC) 1348 focuses on understanding how these dynamic cellular interfaces are formed and how they control decision-making in cells and tissues.
We have developed a comprehensive strategy combining molecular modeling, structural biology, biochemistry, organic synthesis, genetics, cellular and developmental biology. This approach aims to unravel the molecular mechanisms governing cellular interactions and responses in individual cells as well as in multicellular organisms. Leveraging advances in high-resolution imaging, optogenetics, single-cell technologies, synthetic biology, and engineering, CRC 1348 aims to not only understand but also to precisely manipulate dynamic processes at the plasma membrane. Our goal is to provide a deep understanding of the molecular principles that govern cellular interface formation and function, setting the foundation for future efforts to recreate biological complexity from the bottom up.

Registration is now open!
Secure your spot for the international Meeting “Mechanochemical signals at cellular interfaces” from May 27–29, 2026!
More informationen and registration here.

Exciting seminar with Kent Søe about "The “memory” of human osteoclasts - implications for aging, disease, and treatment".
Click here for more information.

Viele Prozesse in der Natur erzeugen komplexe Muster, ohne dass eine zentrale Steuerung erforderlich ist: Vögel bilden Schwärme, Bienen errichten Waben, Schnecken bilden spiralförmige Schalen, und die Kerne im Blütenstand der Sonnenblume ordnen sich symmetrisch an. Das zugrunde liegende Prinzip nennt man „Selbstorganisation“. Auch in unserem Körper entstehen viele Strukturen durch das zufällige Zusammenspiel kleinerer Bausteine. In diesem Vortrag möchte ich mithilfe von Beispielen aus der Natur und aus der Arbeit meiner Forschungsgruppe das Konzept der Selbstorganisation vorstellen, und seine Bedeutung für biologische Systeme erläutern.

The CRC 1348 office is located in the Multiscale Imaging Center (MIC). Our seminars take place in the MIC auditorium.
From Münster central station (Münster Westf Hbf) you can reach the MIC by bus in around 30 minutes.
Bus stops:
(Status as of November 2023)
(Status as of November 2023)